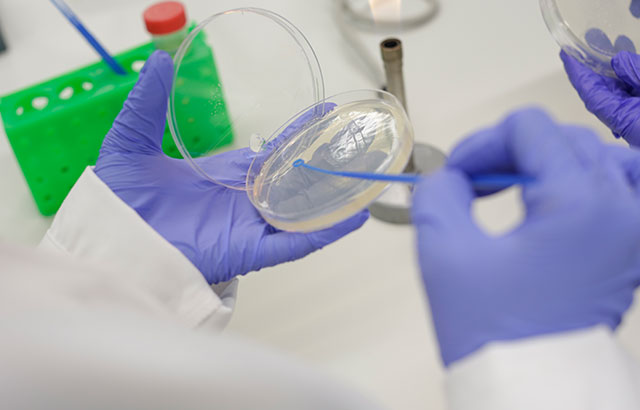
iBSc Pharmacology and Innovative Therapeutics

Undergraduate Programmes
Pharmacology teaching and the MBBS
The William Harvey Research Institute (WHRI) has a major commitment to pharmacology teaching in the MBBS undergraduate curriculum at Queen Mary University of London. In the early years, the primary focus is on basic pharmacology where our teaching is coordinated with that in biochemistry, physiology and pathology to provide students with a strong grounding in the fundamental sciences.
In the senior MBBS years, the WHRI leads clinical pharmacology, prescribing and therapeutics training. We have developed an extremely successful multi-disciplinary teaching programme that ensures our graduates competently meet the difficult challenges of prescribing medicines safely and effectively. The Prescribing Safety Assessment (PSA), the national examination that must be passed by all new doctors before they can prescribe for patients in their care, is taken by all final-year medical students in the UK. Our students have a one hundred percent success record to date.

.png)